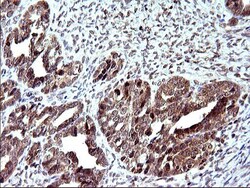

CF507108
antibody from Invitrogen Antibodies
Targeting: EMC8
C16orf2, C16orf4, COX4NB, FAM158B, NOC4
Antibody data
- Antibody Data
- Antigen structure
- References [0]
- Comments [0]
- Validations
- Western blot [2]
- Immunohistochemistry [11]
Submit
Validation data
Reference
Comment
Report error
- Product number
- CF507108 - Provider product page

- Provider
- Invitrogen Antibodies
- Product name
- COX4NB Monoclonal Antibody (OTI2A4), TrueMAB™
- Antibody type
- Monoclonal
- Antigen
- Recombinant full-length protein
- Reactivity
- Human
- Host
- Mouse
- Isotype
- IgG
- Antibody clone number
- OTI2A4
- Vial size
- 100 µg
- Concentration
- 1 mg/mL
- Storage
- -20° C, Avoid Freeze/Thaw Cycles
No comments: Submit comment
Supportive validation
- Submitted by
- Invitrogen Antibodies (provider)
- Main image

- Experimental details
- HEK293T cells were transfected with the pCMV6-ENTRY control (Left lane) or pCMV6-ENTRY COX4NB (RC200296, Right lane) cDNA for 48 hrs and lysed. Equivalent amounts of cell lysates (5 µg per lane) were separated by SDS-PAGE and immunoblotted with anti-COX4N. Positive lysates LY416880 (100 µg) and LC416880 (20 µg) can be purchased separately from OriGene.
- Submitted by
- Invitrogen Antibodies (provider)
- Main image

- Experimental details
- HEK293T cells were transfected with the pCMV6-ENTRY control (Left lane) or pCMV6-ENTRY COX4NB (RC200296, Right lane) cDNA for 48 hrs and lysed. Equivalent amounts of cell lysates (5 µg per lane) were separated by SDS-PAGE and immunoblotted with anti-COX4N. Positive lysates LY416880 (100 µg) and LC416880 (20 µg) can be purchased separately from OriGene.
Supportive validation
- Submitted by
- Invitrogen Antibodies (provider)
- Main image
- Experimental details
- Immunohistochemical staining of paraffin-embedded Adenocarcinoma of Human ovary tissue using anti-COX4NB mouse monoclonal antibody. (Heat-induced epitope retrieval by 10mM citric buffer, pH6.0, 120°C for 3min, TA507108)
- Submitted by
- Invitrogen Antibodies (provider)
- Main image

- Experimental details
- Immunohistochemical staining of paraffin-embedded human pancreas tissue within the normal limits using anti-COX4NB mouse monoclonal antibody. (Heat-induced epitope retrieval by 10mM citric buffer, pH6.0, 120°C for 3min, TA507108)
- Submitted by
- Invitrogen Antibodies (provider)
- Main image

- Experimental details
- Immunohistochemical staining of paraffin-embedded Carcinoma of Human pancreas tissue using anti-COX4NB mouse monoclonal antibody. (Heat-induced epitope retrieval by 10mM citric buffer, pH6.0, 120°C for 3min, TA507108)
- Submitted by
- Invitrogen Antibodies (provider)
- Main image

- Experimental details
- Immunohistochemical staining of paraffin-embedded human endometrium tissue within the normal limits using anti-COX4NB mouse monoclonal antibody. (Heat-induced epitope retrieval by 10mM citric buffer, pH6.0, 120°C for 3min, TA507108)
- Submitted by
- Invitrogen Antibodies (provider)
- Main image

- Experimental details
- Immunohistochemical staining of paraffin-embedded Adenocarcinoma of Human endometrium tissue using anti-COX4NB mouse monoclonal antibody. (Heat-induced epitope retrieval by 10mM citric buffer, pH6.0, 120°C for 3min, TA507108)
- Submitted by
- Invitrogen Antibodies (provider)
- Main image

- Experimental details
- Immunohistochemical staining of paraffin-embedded human prostate tissue within the normal limits using anti-COX4NB mouse monoclonal antibody. (Heat-induced epitope retrieval by 10mM citric buffer, pH6.0, 120°C for 3min, TA507108)
- Submitted by
- Invitrogen Antibodies (provider)
- Main image

- Experimental details
- Immunohistochemical staining of paraffin-embedded Carcinoma of Human bladder tissue using anti-COX4NB mouse monoclonal antibody. (Heat-induced epitope retrieval by 10mM citric buffer, pH6.0, 120°C for 3min, TA507108)
- Submitted by
- Invitrogen Antibodies (provider)
- Main image

- Experimental details
- Immunohistochemical staining of paraffin-embedded human lymph node tissue within the normal limits using anti-COX4NB mouse monoclonal antibody. (Heat-induced epitope retrieval by 10mM citric buffer, pH6.0, 120°C for 3min, TA507108)
- Submitted by
- Invitrogen Antibodies (provider)
- Main image

- Experimental details
- Immunohistochemical staining of paraffin-embedded human lymphoma tissue using anti-COX4NB mouse monoclonal antibody. (Heat-induced epitope retrieval by 10mM citric buffer, pH6.0, 120°C for 3min, TA507108)
- Submitted by
- Invitrogen Antibodies (provider)
- Main image

- Experimental details
- Immunohistochemical staining of paraffin-embedded Adenocarcinoma of Human colon tissue using anti-COX4NB mouse monoclonal antibody. (Heat-induced epitope retrieval by 10mM citric buffer, pH6.0, 120°C for 3min, TA507108)
- Submitted by
- Invitrogen Antibodies (provider)
- Main image

- Experimental details
- Immunohistochemical staining of paraffin-embedded human Kidney tissue within the normal limits using anti-COX4NB mouse monoclonal antibody. (Heat-induced epitope retrieval by 10mM citric buffer, pH6.0, 120°C for 3min, TA507108)
 Explore
Explore Validate
Validate Learn
Learn Western blot
Western blot